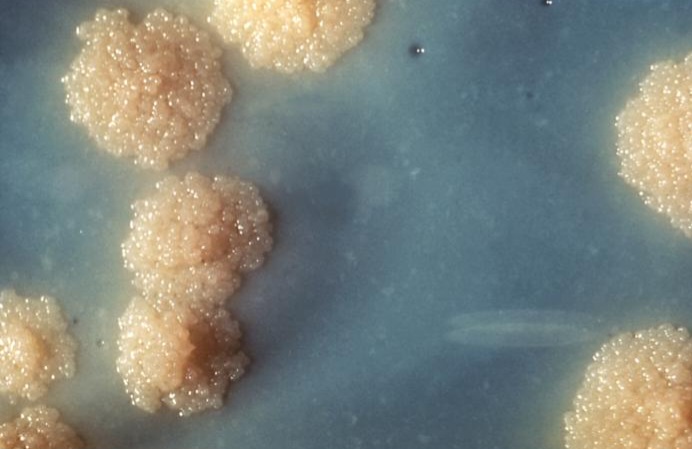

ಬೆಂಗಳೂರು, ಜೂ.27 www.bengaluruwire.com : ವಿಶ್ವಾದ್ಯಂತ ಕ್ಷಯರೋಗದಿಂದ ಲಕ್ಷಾಂತರ ಮಂದಿ ವರ್ಷಂಪ್ರತಿ ಮೃತಪಡುತ್ತಿದ್ದಾರೆ. ಇಂತಹ ಹೊತ್ತಿನಲ್ಲಿ ಭಾರತೀಯ ವಿಜ್ಞಾನ ಸಂಸ್ಥೆ (IISC)ಯ ಬಯೋ ಎಂಜಿನಿಯರಿಂಗ್ (Bio Engineering) ವಿಭಾಗ ಕ್ಷಯರೋಗಕ್ಕೆ ಪರಿಣಾಮಕಾರಿ ಚಿಕಿತ್ಸೆಗೆ ಅನುಕೂಲವಾಗುವ ನಿಟ್ಟಿನಲ್ಲಿ 3ಡಿ ಹೈಡ್ರೋಜೆಲ್ ಕಲ್ಚರ್ ವ್ಯವಸ್ಥೆ (3D Hydrogel Culture System) ಯನ್ನು ಅಭಿವೃದ್ಧಿಪಡಿಸಿದೆ.
ಕ್ಷಯರೋಗಿಗಳಲ್ಲಿ ಬ್ಯಾಕ್ಟಿರಿಯಾಗಳಿಂದ ಶ್ವಾಸಕೋಶಕ್ಕೆ ಯಾವ ಪ್ರಮಾಣದಲ್ಲಿ ಸೋಂಕು ಹರಡುತ್ತಿದೆ ಎಂಬುದನ್ನು ಕರಾರುವಾಕ್ಕಾಗಿ ಪತ್ತೆ ಮಾಡಲು ಸಾಧ್ಯವಾಗುವ ಸರಳ ವಿಧಾನವಾಗಿದೆ.
ಈ ಹೈಡ್ರೋಜೆಲ್ ವ್ಯವಸ್ಥೆಯು ಸಸ್ತನಿಗಳಲ್ಲಿನ ಶ್ವಾಸಕೋಶದ ಪರಿಸರವನ್ನು ಅನುಕರಿಸುತ್ತದೆ. ಅಲ್ಲದೇ, ಶ್ವಾಸಕೋಶದ ಕೋಶಗಳಿಗೆ ಹೇಗೆ ಬ್ಯಾಕ್ಟಿರಿಯಾವನ್ನು ಅಂಟಿಸುತ್ತದೆ ಎಂಬುದನ್ನು ಪತ್ತೆ ಮಾಡಲು ಮತ್ತು ಮುಂದುವರೆದ ಅಧ್ಯಯನ ನಡೆಸಲು ಶಕ್ತಿಶಾಲಿ ವೇದಿಕೆಯನ್ನು ಕಲ್ಪಿಸಿ ಕೊಡಲಿದೆ. ಜತೆಗೆ ಕ್ಷಯಕ್ಕೆ ಹೇಗೆ ಚಿಕಿತ್ಸೆ ನೀಡಬೇಕು ಮತ್ತು ಅದರ ಚಿಕಿತ್ಸೆಗೆ ಬಳಸುವ ಪರಿಣಾಮಕಾರಿ ವಿಧಾನಗಳನ್ನೂ ಇದರ ಮೂಲಕ ಪರೀಕ್ಷಿಸಬಹುದಾಗಿದೆ ಎಂದು ಹೊಸ ಐಐಎಸ್ ಸ್ಸಿಯ ಬಯೋ ಎಂಜಿನಿಯರಿಂಗ್ ವಿಭಾಗದ ಸಂಶೋಧಕರು ಹೇಳುತ್ತಾರೆ.

‘ಮೈಕೊ ಬ್ಯಾಕ್ಟಿರಿಯಂ ಟ್ಯುಬರ್ ಕ್ಕೂಲೋಸಿಸ್ (MTB- ಎಂಟಬಿ) ಅತ್ಯಂತ ಹಳೆಯ ಬ್ಯಾಕ್ಟಿರಿಯಾ, ಮಾನವನ ದೇಹದಲ್ಲೇ ಒಂದಷ್ಟು ಪ್ರಮಾಣದಲ್ಲಿ ವಿಕಾಸಗೊಂಡಿದೆ ಎಂದು ಬಯೋ ಎಂಜಿನಿಯರಿಂಗ್ ವಿಭಾಗದ ಸಹಾಯಕ ಪ್ರೊಫೆಸರ್ ರಚಿತ್ ಅಗರ್ವಾಲ್ ಹೇಳಿದ್ದಾರೆ.

ಎಂಟಿಬಿ ಸೋಂಕಿನ ಅಧ್ಯಯನಕ್ಕೆ ಚಾಲ್ತಿಯಲ್ಲಿರುವ ಕಸಿ ಮಾದರಿ 2ಡಿ) ಹಲವು ಮಿತಿಗಳನ್ನು ಹೊಂದಿದೆ. ಶ್ವಾಸಕೋಶದ ಪರಿಸರದಲ್ಲಿ ಬ್ಯಾಕ್ಟಿರಿಯಾ ಗಳು ಹೇಗೆ ವರ್ತಿಸುತ್ತವೆ ಎಂಬುದನ್ನು ಮೂರು ಆಯಾಮಗಳಲ್ಲಿ ನಿಖರವಾಗಿ ಅನುಕರಿಸಿ (ಮಿಮಿಕ್) ತೋರಿಸುವುದಿಲ್ಲ. ಏಕೆಂದರೆ ಕಸಿ ಮಾಡುವ ಹಾಳೆಗಳು ಏಕಪದರದ್ದಾಗಿರುತ್ತವೆ. 2ಡಿ ಕಸಿ ಹಾಳೆಗಳಲ್ಲಿ ಕಂಡು ಬರುವ ಫಲಿತಾಂಶಕ್ಕೂ ಶ್ವಾಸಕೋಶವನ್ನು ಆವರಿಸಿರುವ ಅಂಗಾಂಶದ ಬಾಹ್ಯಕೋಶಿಯ ಮ್ಯಾಟ್ರಿಕ್ ಗೂ ಸಾಕಷ್ಟು ವ್ಯತ್ಯಾಸ ಕಂಡುಬರುತ್ತದೆ ಎಂದು ತಿಳಿಸಿದ್ದಾರೆ ಪಿಎಚ್.ಡಿ ವಿದ್ಯಾರ್ಥಿ ವಿಶಾಲ್ ಗುಪ್ತಾ.
2ಡಿ ಕಸಿ ಹಾಳೆಗಳಿಗೂ, ನೈಜ ಶ್ವಾಸಕೋಶದ ಅಂಗಾಂಶಗಳಿಗೂ ಅಜಗಜಾಂತರ ವ್ಯತ್ಯಾಸವಿದೆ. ಒಂದು ಗಟ್ಟಿ ಕಲ್ಲಿಗೂ ಮತ್ತೊಂದು ದಿಂಬಿಗೂ ಹೋಲಿಸಬಹುದು ಎಂದು ಅಗರ್ವಾಲ್ ವಿವರಿಸಿದ್ದಾರೆ.
ರಚಿತ್ ಅಗರ್ವಾಲ್ ಮತ್ತು ವಿಶಾಲ್ ಗುಪ್ತಾ ಸೇರಿ ಈ ವಿನೂತನ 3ಡಿ ಹೈಡೋಜಿಲ್ ಕಲ್ಬರ್ ವ್ಯವಸ್ಥೆಯನ್ನು ಅಭಿವೃದ್ಧಿಪಡಿಸಿದ್ದಾರೆ. ವಿಶೇಷವೆಂದರೆ ಶ್ವಾಸಕೋಶದ ಕೋಶಗಳ ಇಸಿಎಂನಲ್ಲಿರುವ ಮಹತ್ವದ ಅಣು ಹೈಡ್ರೋ ಜೆಲ್ನಲ್ಲೂ ಇರುತ್ತದೆ. 3ಡಿ ಹೈಡೋಜೆಲ್ ಅನ್ನು ಕಾಲಜನ್ ಎಂಬ ಒಂದು ಬಗೆಯ ಪ್ರೋಟೀನ್ನಿಂದ ತಯಾರಿಸಲಾಗುತ್ತದೆ.
ಮೈಕೊ ಬ್ಯಾಕ್ಟಿರಿಯಂ ಟ್ಯುಬರ್ಕ್ಕೂಲೋಸಿಸ್ (ಬ್ಯಾಕ್ಷೀರಿಯಾ) ಹೈಡ್ರೋಜೆಲ್ಗೆ ಸೋಂಕಿದ ಬಳಿಕ ಅದರ ಬೆಳವಣಿಗೆ ಹೇಗೆ ಸಾಗುತ್ತದೆ ಎಂಬುದನ್ನು ಅಧ್ಯಯನ ತಂಡ ಎರಡರಿಂದ ಮೂರು ವಾರಗಳ ಕಾಲ ಗಮನಿಸಿದೆ. ಈ ವ್ಯವಸ್ಥೆಯಲ್ಲಿ ಸಸ್ತನಿಗಳ ಕೋಶ ಮೂರು ವಾರಗಳ ಕಾಲ ಬದುಕುಳಿದರೆ, ಈಗಿನ 2ಡಿ ವ್ಯವಸ್ಥೆಯಲ್ಲಿ ನಾಲ್ಕರಿಂದ ಏಳು ದಿನಗಳು ಮಾತ್ರ ಬದುಕುಳಿಯಬಲ್ಲವು. ಅಂದರೆ ದೇಹದಲ್ಲಿ ಈ ರೋಗಕಾರಕ ತೀರಾ ಮಂದಗತಿಯಲ್ಲಿ ಬೆಳೆಯುತ್ತವೆ ಎಂಬುದು ಗಮನಕ್ಕೆ ಬಂದಿದೆ ಎನ್ನುತ್ತಾರೆ ಅಗರ್ವಾಲ್.
ಈ 3ಡಿ ಹೈಡೋಜೆಲ್ ಕಲ್ಟರ್ ವ್ಯವಸ್ಥೆಯ ಮೇಲೆ ಪೇಟೆಂಟ್ ಪಡೆಯಲು ಅರ್ಜಿಯನ್ನು ಸಲ್ಲಿಸಿದೆ. ಇದನ್ನು ರೋಗಿಗಳಲ್ಲಿ ಬ್ಯಾಕ್ಟಿರಿಯಾ ಬೆಳವಣಿಗೆ ಮತ್ತು ಔಷಧ ಪರೀಕ್ಷೆಗೆ ಬಳಸಬಹುದಾಗಿದೆ. ಉದ್ಯಮಗಳು ದೊಡ್ಡ ಪ್ರಮಾಣದಲ್ಲಿ ತಯಾರಿಸಿ ಮಾರುಕಟ್ಟೆಗೆ ಬಿಡುಗಡೆ ಮಾಡಬಹುದು ಎಂದು ಐಐಎಸ್ ಸ್ಸಿಯ ಬಿಇ ವಿಭಾಗದ ಸಂಶೋಧನಾರ್ಥಿಗಳು ಹೇಳಿದ್ದಾರೆ.
ಎಂಟಿಬಿ ಅತ್ಯಂತ ಅಪಾಯಕಾರಿ ಬ್ಯಾಕ್ಟೀರಿಯಾ :
ಮೈಕೋಬ್ಯಾಕ್ಟೀರಿಯಂ ಟ್ಯುಬರ್ ಕ್ಯುಲೋಸಿಸ್ (Mtb) ಒಂದು ಅಪಾಯಕಾರಿ ಬ್ಯಾಕ್ಟೀರಿಯಾ. ಪ್ರಾಥಮಿಕವಾಗಿ ಶ್ವಾಸಕೋಶಗಳಿಗೆ ಸೋಂಕು ತರುತ್ತದೆ. 2022 ರಲ್ಲಿ, ಇದು 10.6 ದಶಲಕ್ಷ ಜನರ ಮೇಲೆ ಪರಿಣಾಮ ಬೀರಿತು ಮತ್ತು 1.3 ದಶಲಕ್ಷ ಜನರ ಸಾವುಗಳಿಗೆ ಕಾರಣವಾಯಿತು ಎನ್ನುತ್ತಿವೆ ವಿಶ್ವ ಆರೋಗ್ಯ ಸಂಸ್ಥೆ (WHO) . “ಇದು ತುಂಬಾ ಹಳೆಯ ದೋಷವಾಗಿದೆ ಮತ್ತು ಇದು ನಮ್ಮೊಂದಿಗೆ ಸ್ವಲ್ಪಮಟ್ಟಿಗೆ ವಿಕಸನಗೊಂಡಿದೆ” ಎಂದು ಬಿಇ ನಲ್ಲಿ ಅಸೋಸಿಯೇಟ್ ಪ್ರೊಫೆಸರ್ ಮತ್ತು ಸುಧಾರಿತ ಹೆಲ್ತ್ಕೇರ್ ಮೆಟೀರಿಯಲ್ಸ್ನ ಲೇಖಕ ರಚಿತ್ ಅಗರ್ವಾಲ್ ಹೇಳುತ್ತಾರೆ.




















